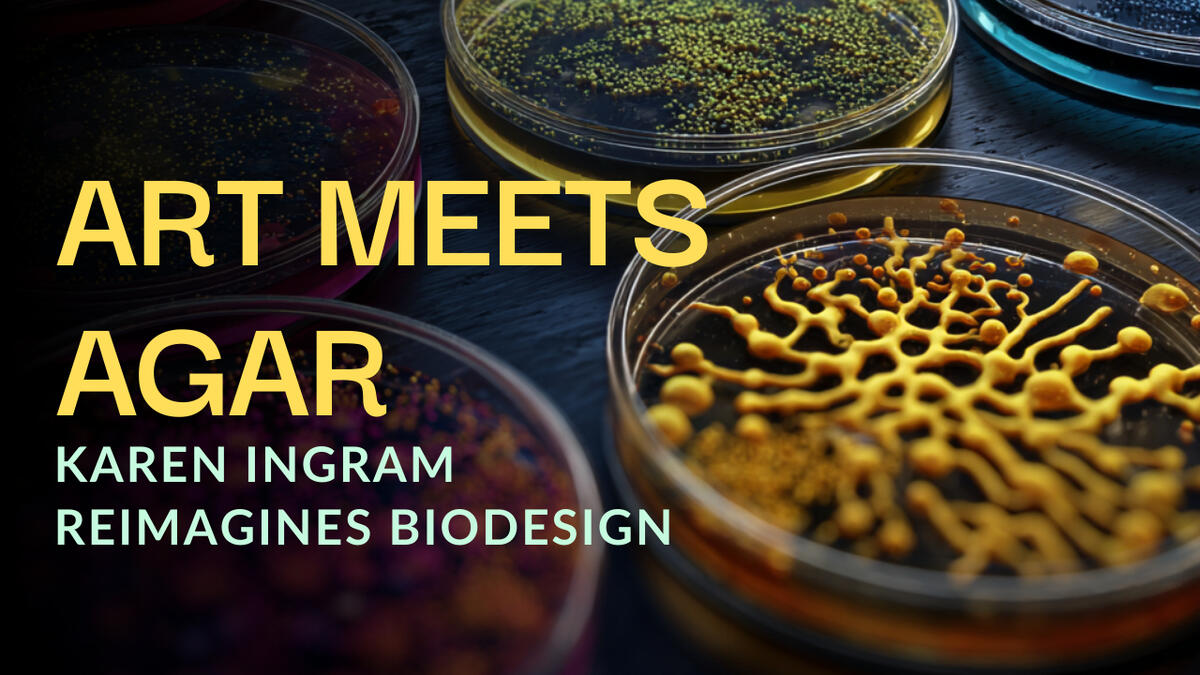

Grow Everything
With Erum Khan & Karl Schmieder
The world's first podcast about biology as technology and its implications across all industries, through wide-ranging conversations with entrepreneurs, investors, designers and scientists.
On all streaming platforms.
Grow Everything ©2023-2025